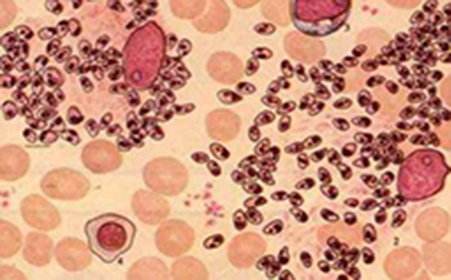
健康热点 疾病 黑热病 本病是由寄生于内脏的杜氏利什曼原虫引起的

黑热病原虫

利士曼原虫又名黑热病 传播者白蛉人畜共患.
图片尺寸1920x1440
在我国,杜氏利什曼原虫引起的历史慢病又被称为黑热病,最常见的是内脏
图片尺寸640x427
黑热病由利什曼原虫所导致,其死亡率较高,需要立即就诊
图片尺寸743x485
热带病专家提醒警惕黑热病死灰复燃
图片尺寸567x444
黑热病原虫
图片尺寸891x714
在我国,杜氏利什曼原虫引起的历史慢病又被称为黑热病,最常见的是内脏
图片尺寸640x427
黑热病
图片尺寸300x220
黑热病原虫课件(ppt精).ppt
图片尺寸1152x864
健康热点 疾病 黑热病 本病是由寄生于内脏的杜氏利什曼原虫引起的
图片尺寸451x280
人体寄生虫学:5-刚地弓形虫和黑热病原虫_第3页
图片尺寸1500x1125
迫切求助:如图所示的黑色虫子是什么?重点是如何消灭?
图片尺寸1438x832
在我国,杜氏利什曼原虫引起的历史慢病又被称为黑热病,最常见的是内脏
图片尺寸640x427
黑虫图片
图片尺寸1024x710
黑热病又名利什曼病,是一种由利什曼原虫感染引起的传染病.
图片尺寸1000x750
人时即可感染利什曼原虫以及某些野生动物后白蛉叮咬患有黑热病的病人
图片尺寸1080x718
在感染利什曼原虫的人群中,每年有7万人不幸逝世,而很多人也因为
图片尺寸553x362
我家地上床上总有小虫,晚上身上痒,以为是蚊子,结果发现了这个,黑色爬
图片尺寸920x1632
074 黑热病原虫ppt
图片尺寸1080x810
请问这是什么虫子? 那个.在线等!
图片尺寸1296x776
黑菌虫
图片尺寸220x165